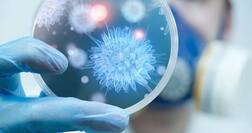
ਕੈਂਸਰ ਨੂੰ ਫੈਲਣ ਤੋਂ ਰੋਕ ਸਕਦੀ ਹੈ ਜ਼ੁਕਾਮ ਦੀ ਦਵਾਈ....

ਸਿਹਤ ਤਸਵੀਰਾਂ
ਸਿਹਤ ਵੀਡੀਓ
ਸਿਹਤ
</>
Embed Code
COPY
CLOSE

ਸਮਾਰਟਫੋਨ ਬੈਟਰੀ ਤੋਂ ਨਿਕਲਦੀਆਂ ਹਨ 100 ਤੋਂ ਵੱਧ ਖ਼ਤਰਨਾਕ ਗੈਸਾਂ
ਵੈੱਬ ਸਟੋਰੀਜ਼
-
 ਸਾਈਟਿਕਾ ਬਿਮਾਰੀ ਵਿੱਚ ਕੀ ਹੁੰਦਾ?
ਸਾਈਟਿਕਾ ਬਿਮਾਰੀ ਵਿੱਚ ਕੀ ਹੁੰਦਾ? -
 ਮਰਦ ਸੌਣ ਤੋਂ ਪਹਿਲਾਂ ਦੁੱਧ ‘ਚ ਮਿਲਾ ਕੇ ਪੀਣ ਆਹ ਚੀਜ਼, ਹੋਣਗੇ ਕਈ ਫਾਇਦੇ
ਮਰਦ ਸੌਣ ਤੋਂ ਪਹਿਲਾਂ ਦੁੱਧ ‘ਚ ਮਿਲਾ ਕੇ ਪੀਣ ਆਹ ਚੀਜ਼, ਹੋਣਗੇ ਕਈ ਫਾਇਦੇ -
 ਪੀਰੀਅਡਸ ਦੇ ਕਿੰਨੇ ਦਿਨ ਬਾਅਦ ਮਾਂ ਬਣਨ ਦੇ ਸਭ ਤੋਂ ਵੱਧ ਚਾਂਸ?
ਪੀਰੀਅਡਸ ਦੇ ਕਿੰਨੇ ਦਿਨ ਬਾਅਦ ਮਾਂ ਬਣਨ ਦੇ ਸਭ ਤੋਂ ਵੱਧ ਚਾਂਸ? -
 ਨਵੇਂ ਸਾਲ ਦੀ ਪਾਰਟੀ ਤੋਂ ਬਾਅਦ ਹੈਂਗਓਵਰ ਤੋਂ ਛੁਟਕਾਰਾ: ਸਿਰਦਰਦ ਲਈ ਛੂ-ਮੰਤਰ ਨੁਸਖੇ
ਨਵੇਂ ਸਾਲ ਦੀ ਪਾਰਟੀ ਤੋਂ ਬਾਅਦ ਹੈਂਗਓਵਰ ਤੋਂ ਛੁਟਕਾਰਾ: ਸਿਰਦਰਦ ਲਈ ਛੂ-ਮੰਤਰ ਨੁਸਖੇ -
 ਘਰ ‘ਚ ਇਦਾਂ ਬਣਾਓ ਸਿਰਕਾ
ਘਰ ‘ਚ ਇਦਾਂ ਬਣਾਓ ਸਿਰਕਾ -
 ਡਾਕਟਰਾਂ ਵੱਲੋਂ ਸਖ਼ਤ ਚੇਤਾਵਨੀ, ਹਾਰਟ ਅਟੈਕ ਦਾ ਸਵੇਰ ਸਮੇਂ ਵੱਧ ਖ਼ਤਰਾ; ਉੱਠਦੇ ਹੀ...
ਡਾਕਟਰਾਂ ਵੱਲੋਂ ਸਖ਼ਤ ਚੇਤਾਵਨੀ, ਹਾਰਟ ਅਟੈਕ ਦਾ ਸਵੇਰ ਸਮੇਂ ਵੱਧ ਖ਼ਤਰਾ; ਉੱਠਦੇ ਹੀ... -
 ਦੰਦਾਂ ਨੂੰ ਕੁਦਰਤੀ ਤਰੀਕੇ ਨਾਲ ਸਫੈਦ ਕਰਨ ਦੇ ਦੇਸੀ ਨੁਸਖੇ – ਘਰੇਲੂ ਉਪਾਅ ਨਾਲ ਚਮਕਦਾਰ ਅਤੇ ਸਿਹਤਮੰਦ ਮੁਸਕਾਨ
ਦੰਦਾਂ ਨੂੰ ਕੁਦਰਤੀ ਤਰੀਕੇ ਨਾਲ ਸਫੈਦ ਕਰਨ ਦੇ ਦੇਸੀ ਨੁਸਖੇ – ਘਰੇਲੂ ਉਪਾਅ ਨਾਲ ਚਮਕਦਾਰ ਅਤੇ ਸਿਹਤਮੰਦ ਮੁਸਕਾਨ -
 ਸਰਦੀਆਂ 'ਚ ਤੁਲਸੀ ਵਾਲੀ ਚਾਹ ਸਿਹਤ ਲਈ ਕੁਦਰਤੀ ਵਰਦਾਨ, ਦੂਰ ਹੁੰਦੀਆਂ ਕਈ ਬਿਮਾਰੀਆਂ
ਸਰਦੀਆਂ 'ਚ ਤੁਲਸੀ ਵਾਲੀ ਚਾਹ ਸਿਹਤ ਲਈ ਕੁਦਰਤੀ ਵਰਦਾਨ, ਦੂਰ ਹੁੰਦੀਆਂ ਕਈ ਬਿਮਾਰੀਆਂ -
 ਬੱਚਿਆਂ ਲਈ ਜੰਕ ਫੂਡ ਬਿਮਾਰੀਆਂ ਦਾ ਘਰ – 10 ਗੰਭੀਰ ਨੁਕਸਾਨ ਜੋ ਮਾਪਿਆਂ ਨੂੰ ਜਾਣਨੇ ਚਾਹੀਦੇ
ਬੱਚਿਆਂ ਲਈ ਜੰਕ ਫੂਡ ਬਿਮਾਰੀਆਂ ਦਾ ਘਰ – 10 ਗੰਭੀਰ ਨੁਕਸਾਨ ਜੋ ਮਾਪਿਆਂ ਨੂੰ ਜਾਣਨੇ ਚਾਹੀਦੇ -
 ਸਰਦੀਆਂ ‘ਚ ਸਰੀਰ ‘ਚ ਦਿਖਣ ਆਹ ਲੱਛਣ ਤਾਂ ਸਮਝ ਜਾਓ ਹੋ ਗਿਆ ਡੀਹਾਈਡ੍ਰੇਸ਼ਨ
ਸਰਦੀਆਂ ‘ਚ ਸਰੀਰ ‘ਚ ਦਿਖਣ ਆਹ ਲੱਛਣ ਤਾਂ ਸਮਝ ਜਾਓ ਹੋ ਗਿਆ ਡੀਹਾਈਡ੍ਰੇਸ਼ਨ
ਚੋਟੀ ਦੀਆਂ ਖ਼ਬਰਾਂ
ABP NEWS GROUP WEBSITES
This website follows the DNPA code of Ethics
© Copyright@2025.ABP Network Private Limited. All rights reserved